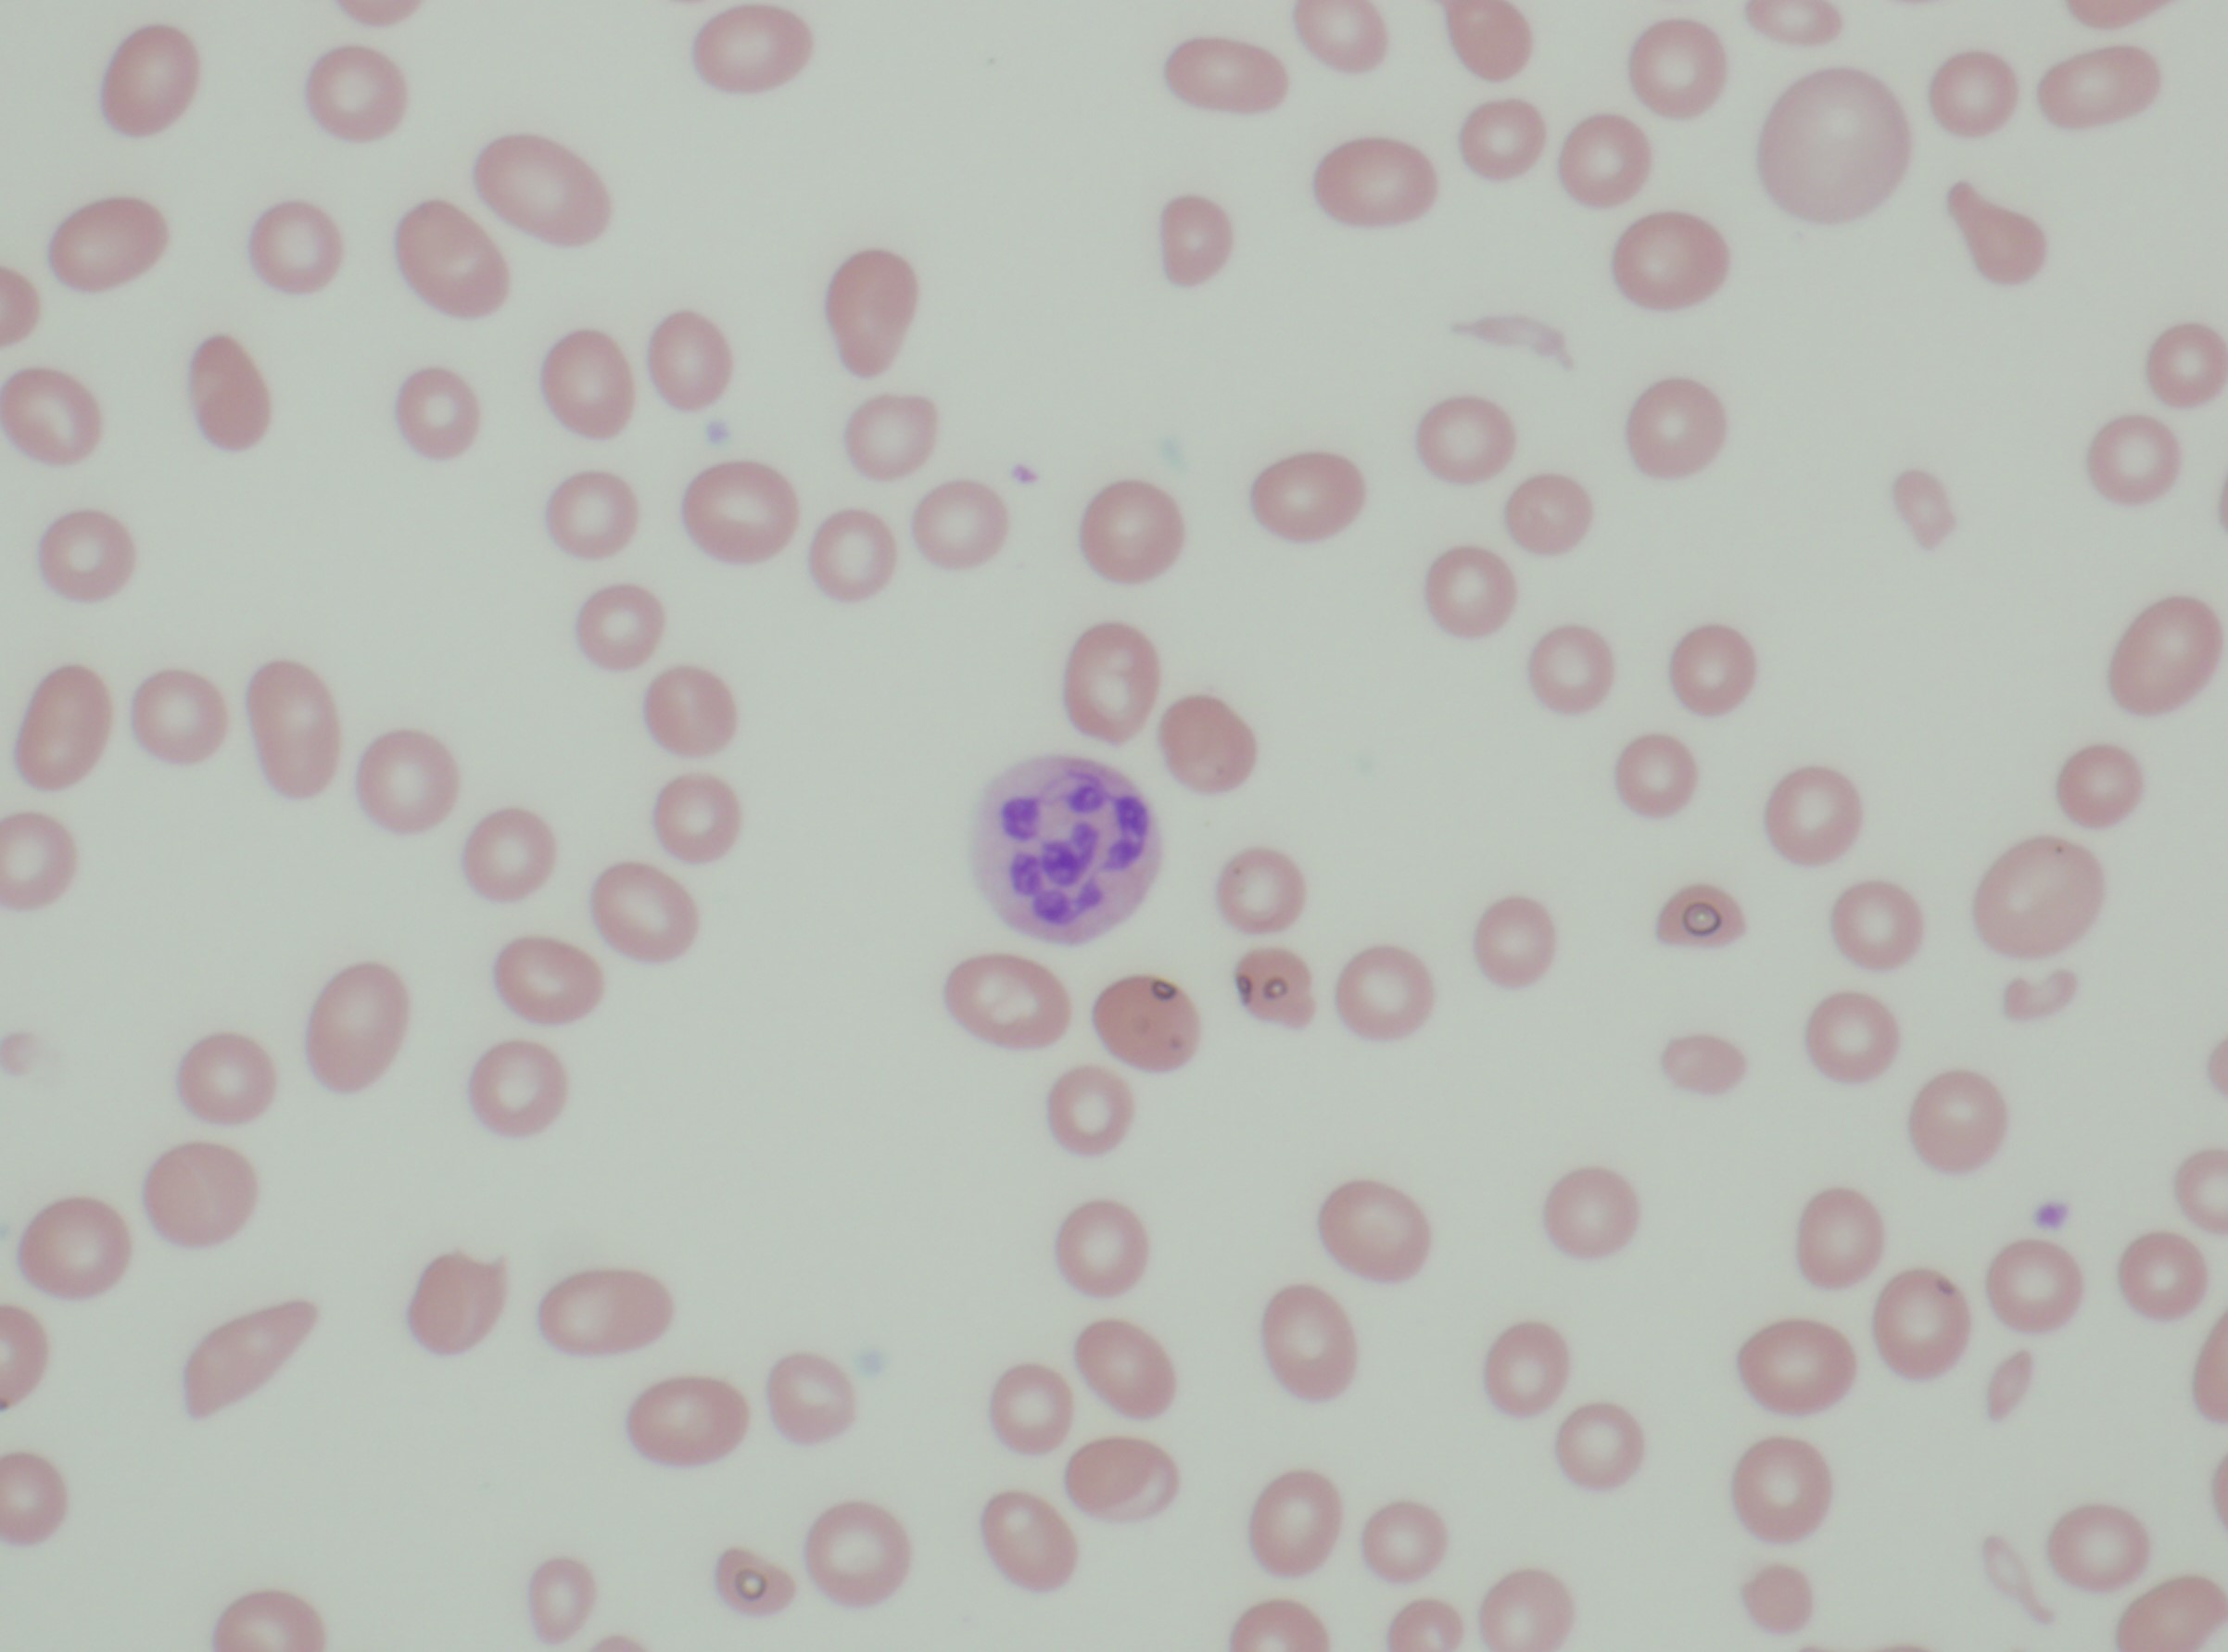

Case Presentation: A 29 year old Hispanic male with no significant past medical history presented to the Emergency Department with new onset jaundice. He also endorsed a constellation of symptoms for several months including weight loss, progressive fatigue, frequent headaches, decreased appetite, daily nausea with occasional emesis, and dark urine. He was not taking any medications and denied use of illicit substances, alcohol or tobacco. He had no dietary restrictions. On admission, his vital signs and physical examination were unremarkable except scleral icterus and pallor. Initial laboratory studies revealed macrocytic anemia (Hemoglobin: 5.2g/dL; hematocrit: 14.6%; MCV 113fl), as well as pancytopenia (white blood cell count: 2.3 K/uL, platelet count: 91 K/uL). Laboratory results also revealed concerns for hemolysis. Further workup revealed normal Vitamin B12 level (706 pg/mL), however serum methylmalonic acid and homocysteine levels were high. Folate level was within normal limits. A direct antiglobin test (Coombs) with IgG was negative. Testing for glucose-6-phosphate dehydrogenase (G6PD) deficiency was negative. Autoimmune workup including ANA, rheumatoid factor, serum immunoglobulins and complements were unremarkable. Infectious workup including blood cultures, urine cultures, hepatitis, HIV, CMV, parvob19, syphilis were negative. CT chest, abdomen and pelvis with contrast was unremarkable. Peripheral smear revealed macrocytic anemia and hypersegmented neutrophils. Presence of Intrinsic factor antibody confirmed the diagnosis of pernicious anemia. He was started on oral supplementation indefinitely and outpatient follow up two months later revealed complete resolution of his symptoms.
Discussion: Pernicious anemia has been reported as the most common cause of severe cobalamin deficiency in adults. This autoimmune disease is characterized by the presence of antibodies against intrinsic factor and parietal cells. Deficiency in Vitamin B12 leads to destruction of immature erythrocytes within the bone marrow. Laboratory findings suggestive of hemolysis include elevated indirect bilirubin, which can present as jaundice. Severe deficiency can also result in thrombocytopenia and leucopenia. We considered a differential which included causes of jaundice, hemolytic anemia and pancytopenia. This included immune mediated processes lupus and G6PD deficiency. The patient was young and thus drug use and infection were considered. Work up provided clear evidence for a diagnosis of Vitamin B12 deficiency secondary to pernicious anemia.
Conclusions: Our patient presented with new onset jaundice, pancytopenia and hemolytic anemia in the setting of Vitamin B12 deficiency secondary to pernicious anemia. Such a constellation of abnormalities can be alarming for clinicians. Through this case report we demonstrate the importance of having high clinical suspicion for vitamin B12 deficiency in patients with these presenting features, even if serum Vitamin B12 levels are normal. Appropriate testing can lead to development of simple treatment plans and ultimately work in the best interest of the patient.